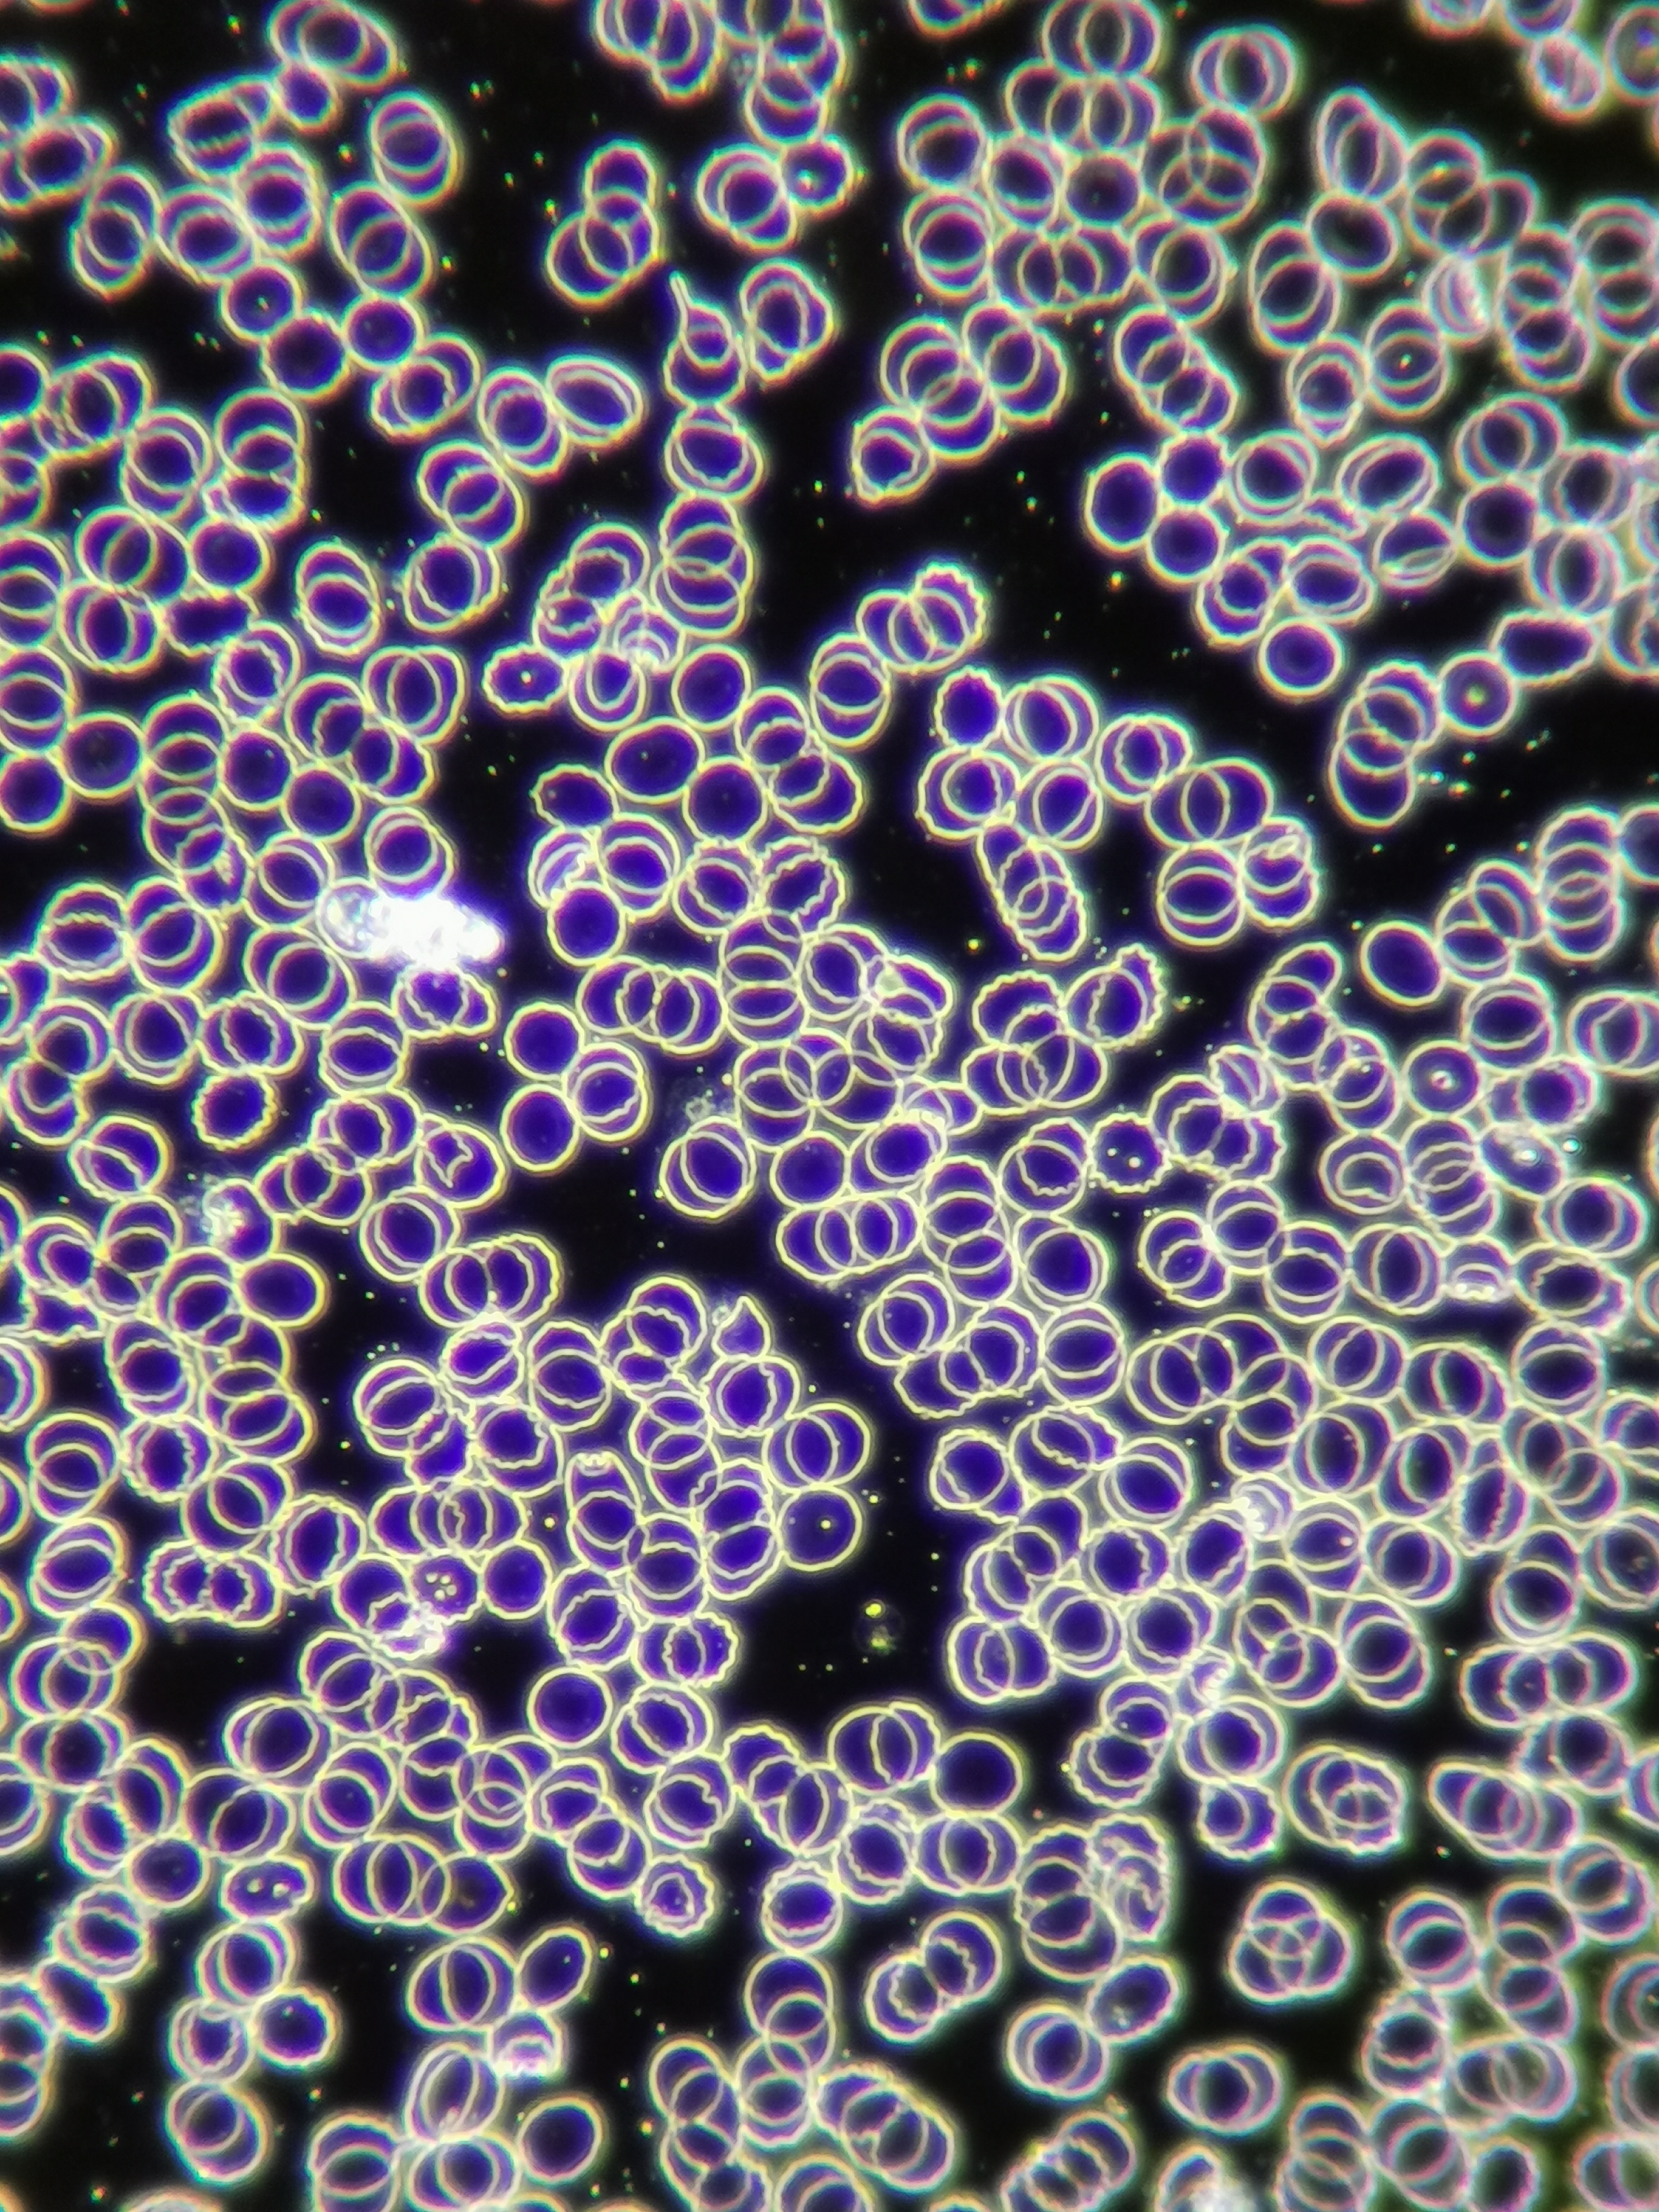
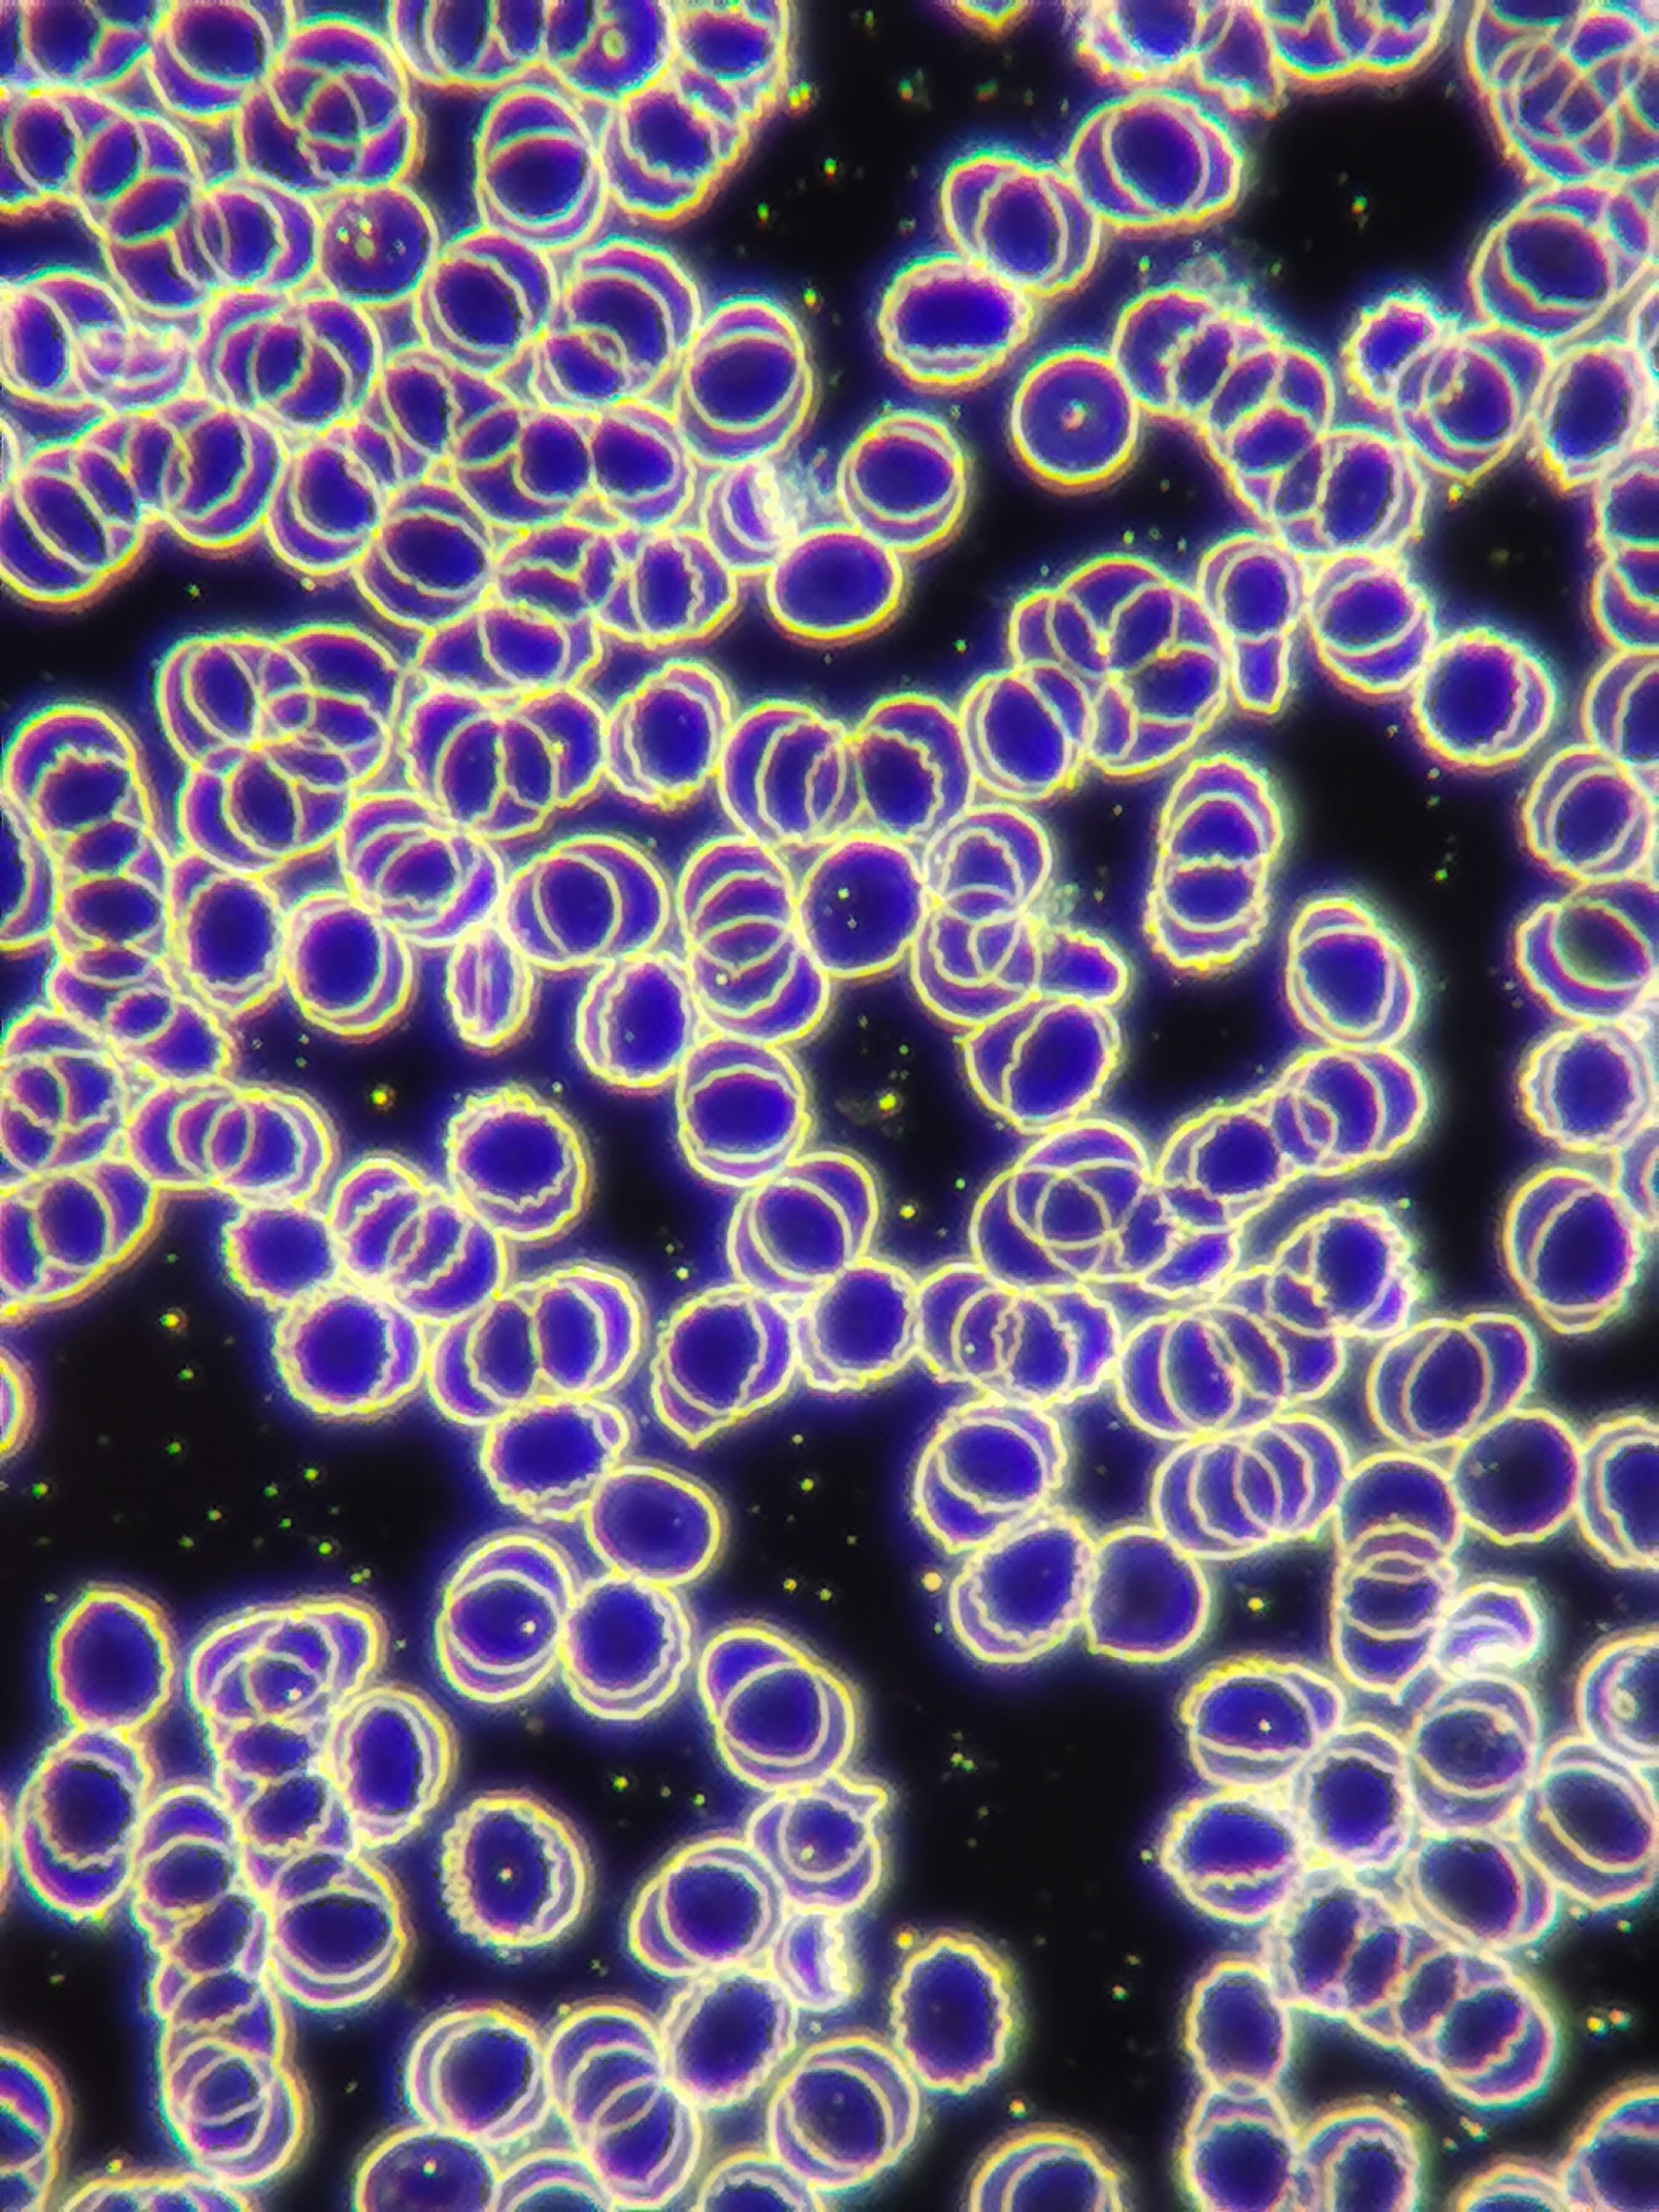

กล้องจุลทรรศน์สำหรับตรวจวิเคราะห์งาน Live Blood Cell Analysis ด้วยกล้องจุลทรรศน์ Dark Field Microscope เพื่อดูโครสร้างของเม็ดเลือดจะสิ่งปลอมปนในเม็ดเลือด
กล้องจุลทรรศน์ ชนิด Dark Field จะต่างจากกล้องจุลทรรศน์ Bright Field ธรรมดาที่ ภาพจากกล้อง Bright Field ให้ภาพสีเหมือนจริง เช่น เม็ดเลือดสีแดง เมื่อติดตั้งระบบ Dark Field เข้ากับตัวเครื่อง พื้นหลังของภาพที่ได้จะมืด และทำให้เห็นส่วนของโครงสร้าง และลักษณะของขอบวัตถุที่เกิดการหักเหของแสงได้ชัดยิงขึ้น
| รายการ | ราคา |
| XENON กล้องจุลทรรศน์ Dark Field N-117DK | 25,000.- |
| XENON กล้องจุลทรรศน์ Dark Field N-117DK พร้อมชุดถ่ายทอดสัญญาณ | 40,000.- |
| OPTIKA กล้องจุลทรรศน์ Dark Field B-383DK | 95,000.- |
| OPTIKA กล้องจุลทรรศน์ Dark Field B-383DK พร้อมชุดถ่ายทอดสัญญาณ | 110,000.- |
กล้องจุลทรรศน์ Dark Field XENON N-117DK ราคาเฉพาะกล้อง Darkfield 25,000 บาท พร้อมชุดถ่ายทอดสัญญาณ 40,000 บาท
ภาพเม็ดเลือด จากกล้องจุลทรรศน์ Dark Field XENON N-117DK
ภาพถ่ายโดยมือถือ Huawei P30 Pro
ที่กำลังขยาย 400X
กล้องจุลทรรศน์ Dark Field OPTIKA B-383DK จากประเทศอิตาลี ระบบไฟ LED ราคาเฉพาะกล้อง Dark Field 95,000 บาท พร้อมชุดถ่ายทอดสัญญาณ 110,000 บาท
ภาพเม็ดเลือด จากกล้องจุลทรรศน์ Dark Field OPTIKA B-383DK
ภาพถ่ายโดยมือถือ Huawei P30 Pro
ภาพเม็ดเลือด จากกล้องจุลทรรศน์ Dark Field OPTIKA B-383DK
ภาพถ่ายโดยมือถือ Huawei P30 Pro
ที่กำลังขยาย 400X
มีทั้งขายปลีก และส่งสามารถสอบถามราคาและรายละเอียดเพิ่มเติมได้ที่
Line ID : @scitrader คลิ๊กเพิ่มเพื่อน
Mail : sale@scitrader.co.th